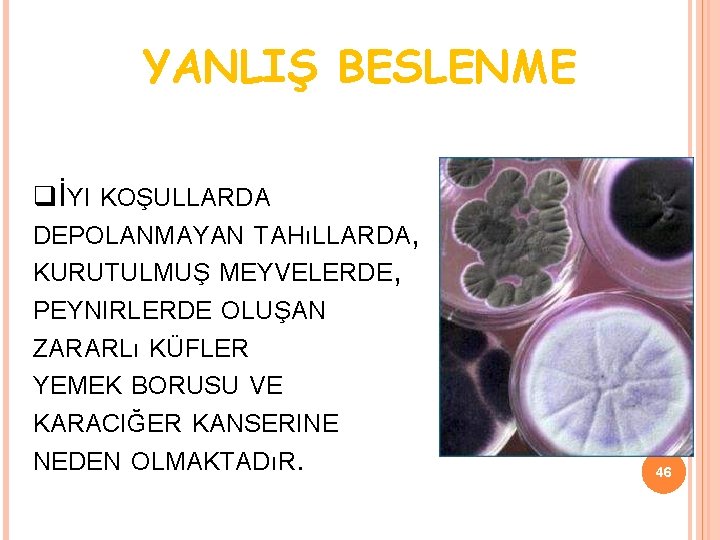
YANLIŞ BESLENME İYI KOŞULLARDA DEPOLANMAYAN TAHıLLARDA, KURUTULMUŞ MEYVELERDE, PEYNIRLERDE OLUŞAN ZARARLı KÜFLER YEMEK BORUSU

SALIKLI YAAM VE BESLENME r Gr Dr eyda

SAĞLIKLI YAŞAM VE BESLENME Öğr. Gör. Dr. Şeyda Çiğdem ÖZKAN OSD Dersi/2019 -2020/Güz Dönemi Dokuzuncu Slayt- 13. Hafta

SAĞLıKSıZ BESLENMENIN YOL AÇTıĞı HASTALıKLAR: OBEZİTE, KANSER, KALPDAMAR HASTALıKLARı VE ENDOKRİN SİSTEMİ BOZUKLUKLARı 11/12/2019

OBEZİTE (ŞİŞMANLIK) • Vücutta fazla miktarda yağ dokusu birikmesi sonucu ortaya çıkan ve mutlaka tedavi edilmesi gereken bir hastalıktır. • Yağ dokularının oranı, diğer dokulara göre artmıştır. 3

ŞİŞMANLIK NASIL SAPTANIR? Bireyin boy ve ağırlık ölçüleri alınıp bununla ilgili standartlarla kıyaslanabilir. BKİ: Ağırlık(kg) Boy(m)2 4

ŞİŞMANLIK NASIL SAPTANIR? BKİ: <20 ise zayıf 20 -25 ise sağlıklı 25 -30 ise hafif şişman 30 -35 ise şişman >35 ise ağır şişman 5

ŞİŞMANLIK NASIL SAPTANIR? Örnek: 1. 5 m boyunda bir kadın kaç kilo olmalıdır? Ağırlık=standart değer x Boy (m)2 20 veya 25 x (1. 5)2 Ağırlık= 45 -56 kg 6

ŞİŞMANLIK NASIL SAPTANIR? Beden kitle indeksiniz 20 ve altında ise zayıfsınız! Bu halinizden memnun olabilirsiniz ancak, normal sınırların altında olduğunuzu sakın unutmayın. Yani siz de sağlığınıza ve beslenmenize dikkat etmek durumundasınız. 7

ŞİŞMANLIK NASIL SAPTANIR? Beden kitle indeksiniz 20 -25 arasında ise sizin durumunuz ideal. Büyük olasılıkla dengeli besleniyorsunuz ve egzersizi ihmal etmiyorsunuz. Aynı şekilde devam etmeniz gerekir. Fakat 25 civarında olmaya başlarsanız, bir şeyler eksik gidiyor demektir. 8

ŞİŞMANLIK NASIL SAPTANIR? Beden kitle indeksiniz 25 -30 arası ise kilolusunuz. Derhal harekete geçilmelidir. Fazla kilolu olmak sizi, şu an için rahatsız etmiyor olabilir, ancak unutmayın vücudunuzda birikmiş olan yağlar size sinsice tuzaklar hazırlıyor olabilir. Beslenmenizi bir kez daha gözden geçiriniz. 9

ŞİŞMANLIK NASIL SAPTANIR? Beden kitle indeksiniz 30 ve üzeri ise tıbben hastasınız demektir. “Ben halimden memnunum “demeyin. Çünkü; siz de sorunlarınızın farkında olmayabilirsiniz. Derhal bir hekimin ve diyetisyenin desteğini almanız gerekmektedir. 10

ŞİŞMANLIK NASIL SAPTANIR? Günümüzde şişmanlık, dünya sağlık örgütü tarafından hastalık olarak kabul edilmiştir. Çünkü şişman bireylerde, metabolik sendrom riski daha fazla olmaktadır. 11

ŞİŞMANLIĞIN ZARARLARI NELERDİR? Ağır bir vücudu taşımak güçtür. Özellikle orta yaşlı ve yaşlılarda ağır vücudun taşınması eklemlerde ağrıların artmasına yol açar. Gençlerin şişman oluşu, onların psikolojik olarak olumsuz etkilenmelerine neden olur. Kas hareketlerinin verimini azaltacağından fiziksel hareketsizliğe yol açar. Kalp damar hastalıkları ve hipertansiyon oluşumuna neden olur. 12 Yaşam süresini kısaltır.

ŞİŞMANLIĞIN NEDENLERİ 1. 2. 3. 4. Uzun süren bir enerji dengesizliği söz konusudur. Fazla yemek yeme Fiziksel hareket azlığı Psikolojik bozukluklar Metabolik ve hormonal bozukluklar 13

ŞİŞMANLIĞIN NEDENLERİ Fazla yemek yeme ü Yenilen yiyeceklerin enerjisi konusunda bilgi sahibi olmama ü Damak zevki ü Maddi yetersizlik sonucu karbonhidratlı gıdaların fazla tüketimi 14

ŞİŞMANLIĞIN NEDENLERİ Fiziksel aktivite azlığı ü Vücut ağırlığı arttıkça hareketlerin kısıtlanması ü İş ortamı nedeniyle sürekli oturuluyor olması ü Yürüyüş alışkanlığının kazanılmaması ü Çocukluk döneminde spor alışkanlığının kazanılmaması 15

ŞİŞMANLIĞIN NEDENLERİ Psikolojik bozukluk ü Depresyon ü Kilo fazlalığı nedeniyle alay edilme ü Aile ve arkadaş çevresince sürekli eleştirilme 16

ŞİŞMANLIĞIN NEDENLERİ Metabolik ve hormonal bozukluklar ü Bozulmuş glikoz toleransı ü Diyabet ü Hipotroid ü Polikistik over sendromu 17

ŞİŞMANLIĞIN NEDENLERİ Kalıtım Yapılan bir araştırmada, normal ağırlıkta olan anne ve babanın çocukları arasındaki şişmanlık oranı % 8 -9 iken, anne babadan biri şişman olan çocuklardaki şişmanlık oranı %40 bulunmuştur. 18

ŞİŞMANLIK Kalp hastalıkları, diyabet, hipertansiyon, kanser gibi hastalıklara zemin hazırlar. Kazalara neden olur. Hareket sınırlandığı için yaşam kalitesini düşürür. Yaşam süresini kısaltır. 19

ŞİŞMANLIK Şişmanlamak kolay, zayıflamak zordur. Şişman çocuk sağlıklı çocuk demek değildir. Çocuklukta alınan kiloları yetişkinlikte vermek çok zordur. Çocukluktan itibaren dengeli beslenme alışkanlığı kazandıralım. 20

ŞİŞMANLIK Sadece %5 -10’ luk bir kilo kaybı Kiloyla ilişkili metabolik hastalıkların riskini Kan basıncını Kan glikoz düzeyini Kandaki Erken kolesterol ve trigliseritleri ölüm riskini AZALTIR. 21

SAĞLIKLI ZAYIFLAMA UYGULANACAK ADIMLAR 1. 2. 3. 4. 5. 6. İÇİN Kan rutinleri ve troid fonksiyon testleri yapılmalı Bireyin bazal metabolizma hızı hesaplanmalı Bireye, harcadığı enerjiden daha az enerji içeren dengeli beslenme programı hazırlanmalı Besinler, protein, karbonhidrat, yağ, vitamin ve minerallerce yeterli olmalı Doyurucu ve bireyin beslenme alışkanlığına uygun besinler seçilmeli 22 Fiziksel aktivite arttırılmalıdır.

YİYECEK SEÇİMİNDE DİKKAT EDİLMELİDİR? NELERE Şeker, tatlı, pilav, makarna, börek gibi yiyeceklerin miktarı azaltılmalı Yemeklere eklenen yağ miktarı azaltılmalı, etli yemeklere yağ ilavesi yapılmamalı Kızartılmış yiyecekler tercih edilmemeli Yemekten önce su ve yağsız salata tüketilmeli Kepekli, çavdar veya tam tahıllı ekmek tercih edilmeli Çay, kahve şekersiz tüketilmeli İçecek olarak su, maden suyu, ayran tercih edilmeli Kuru baklagiller ve bulgur daha çok tüketilmeli Meyve suyu yerine meyve tüketilmeli 23

ŞİŞMANLIK İLE BAŞA ÇIKMA Hızlı zayıflayan kişi verdiği kiloları kısa sürede geri alır. Unutulmamalıdır ki zayıflamada hedef süre değil, kaybedilen ağırlığın uzun süre korunmasıdır. Bu nedenle haftada 0. 5 -1 kg veya ayda 3 -4 kg dan fazla kilo verilmemelidir. 24

ŞİŞMANLIK İLE BAŞA ÇIKMA Obezite ile mücadele, birkaç hafta veya birkaç ay ile sınırlı “mucize diyetler” ile ya da “gelin sizi 15 günde tığ gibi yapalım” merkezleri ile başarılabilecek iş değildir. Başarı; sadece sizin kendi isteğiniz ve diyetisyeninizin yardımı ile, yaşamınızda yapacağınız küçük ama önemli değişikliklerle sağlanabilir. 25

NASIL KİLO VERİLİR? Yediğiniz besin miktarını azaltın Aralarda atıştırmaktan kaçının Düzenli yiyin, öğün atlamayın Şekerli ve yağlı besinlerden kaçının Yiyecekleri yavaş yiyin İyi çiğneyin Yemek tabağınızı küçültün Salata tabağınızı büyütün Her öğün öncesi iki bardak su için Alkollü içki, hazır meyve suyu yerine su, ayran, maden suyu tercih edin Aktivitenizi arttırın 26

DESTEK ÜRÜNLER KULLANILMALI MI? Ağrı kesicilerin bile yan etkisini düşünecek olursak, zayıflama ilaçları kullanılmamalıdır. Sıvı ile birlikte alınarak uzun süre tokluk hissi veren diyet lifleri kullanılabilir. Omega 3 yağ asidi içeren tabletler kullanılabilir. Keten tohumu, ceviz, kepek, yulaf kepeği kullanılabilir. 27

SON SÖZ… Lütfen beden kütle indeksinizi hesaplayın. En az 12 kg fazlalığınız varsa; Unutmayınız ki SIRTINIZDA BİR AYGAZ TÜPÜ taşımaktasınız. 28 KAYNAK: Uzm. Dyt. Sermin ÖZER

KANSER • Sağlıksız beslenme sonucu ortaya çıkan en tehlikeli hastalıklardan biri de kanserdir. • Çağımızın vebası olarak adlandırılan kanser, tedavisi geç kalındığı taktirde mümkün olamayan bir hastalıktır. 29

HÜCRE NEDİR? Vücudumuzda tüm organlar hücrelerden oluşur. Hücreler vücudumuzun en küçük yapıtaşlarıdır. 30

HÜCRE NEDİR? Sağlıklı vücut hücreleri bölünebilme yeteneğine sahiptirler. Her hücrenin hayatı boyunca belli bir bölünebilme sayısı vardır. 31

KANSER NEDİR? Hücrelerin kontrolsüz olarak ve sürekli çoğalmaları sonucu oluşan, tedavi edilmediğinde yakındaki ve uzaktaki organlara yayılan bir hastalıktır. 32

KANSER OLUŞUMU Etkenler ile hücrenin anormal çoğalması Normal hücre Tümörün kan dolaşımı sisteminden beslenmesi Tümörün kan dolaşım sistemi ile diğer organlara hücum etmesi 33

KANSERİN NEDENLERİ Bazı Virüsler Sigara Radyasyon Alkol Kimyasal Maddeler Yanlış Beslenme Çevre Kirliliği Hareketsiz Yaşam Aşırı Güneş Işını-Solaryum Aşırı Röntgen Işını Genetik ve Yaş 34

SİGARA Kanserin en önemli nedeni sigara kullanmaktır. Sigara dumanına maruz kalmakta sigara içmek kadar risklidir. 35

SİGARA AKCIĞER KANSERI BAŞTA OLMAK ÜZERE, GıRTLAK AĞıZ BOŞLUĞU-YEMEK BORUSU KANSERI MIDE-BARSAK KANSERI PANKREAS KANSERI BÖBREK VE MESANE KANSERI MEME VE RAHIM KANSERI gibi birçok kansere neden olmaktadır. 36

ALKOL TEK BAŞıNA KANSER NEDENI OLMAKLA BIRLIKTE SIGARA ILE ALıNDıĞıNDA RISK DAHA DA ARTMAKTADıR. 37

ALKOLÜN NEDEN OLDUĞU KANSERLER KARACIĞER KANSERI AĞıZ, BAŞ VE BOYUN KANSERLERI YEMEK BORUSU KANSERI GıRTLAK KANSERI KALıNBAĞıRSAK-REKTUM KANSERIDIR 38

YANLIŞ BESLENME YANLıŞ BESLENME BIRÇOK HASTALıĞA NEDEN OLMAKLA BIRLIKTE KANSERIN DE BAŞLıCA NEDENLERI ARASıNDADıR. 39

YANLIŞ BESLENME HAYVANSAL GıDALARıN FAZLA TÜKETIMI MEME, RAHIM, PROSTAT, KALıNBARSAK-REKTUM, PANKREAS VE BÖBREK KANSERINE NEDEN OLMAKTADıR. 40 YAĞSıZ ET TÜKETIMI KANSER RISKINI ARTTıRMAZ.

YANLIŞ BESLENME HAYVANSAL BESINLERIN YANLıŞ HAZıRLANMASı KANSERE NEDEN OLMAKTADıR. KıZARTıLMıŞ ET, TÜTSÜLENMIŞ ET, KÖMÜR ATEŞINDE PIŞIRILMIŞ ET, BALıK 41

YANLIŞ BESLENME FAZLA YAĞ TÜKETIMI MEME, PROSTAT, TESTIS, RAHIM, PANKREAS, KALıN BARSAK-REKTUM KANSER RISKINI ARTTıRMAKTADıR. ÖZELLIKLE; KıZARTMALARıN FAZLA TÜKETIMI SıVı YAĞ YERINE KATı YAĞLARıN TÜKETIMI KANSERDEN KORUYUCU YAĞLARıN KULLANıLMAMASı(ZEYTINYAĞı GIBI…) 42

YANLIŞ BESLENME TUZ VE SALAMURA GIBI TUZLU GıDALARıN FAZLA TÜKETIMI MIDE KANSERI RISKINI ARTTıRMAKTADıR. ŞEKERLI GıDALARıN FAZLA TÜKETIMI (ÖZELLIKLE ÇAY ŞEKERI) KOLON, REKTUM VE PANKREAS KANSERI RISKINI ARTTıRMAKTADıR. 43

YANLIŞ BESLENME HAZıR GıDALARDA BULUNAN KORUYUCU KATKı MADDELERI KANSER OLUŞUMUNDA ÖNEMLI BIR ETKIYE SAHIPTIR. KATKı MADDELERI MIDE VE YEMEK BORUSU KANSERLERINI ARTTıRMAKTDıR. ÖR: SALAM, SOSIS, CIPS, BISKÜVI GIBI… 44

YANLIŞ BESLENME AZ POSALı BESLENME KANSER RISKINI ARTTıRıR. POSALı YIYECEKLERIN TÜKETIMI KALıNBARSAKREKTUM KANSERLERINI ÖNLEMEKTEDIR. 45
YANLIŞ BESLENME İYI KOŞULLARDA DEPOLANMAYAN TAHıLLARDA, KURUTULMUŞ MEYVELERDE, PEYNIRLERDE OLUŞAN ZARARLı KÜFLER YEMEK BORUSU VE KARACIĞER KANSERINE NEDEN OLMAKTADıR. 46

YANLIŞ BESLENME BESINLERIN SAĞLıKSıZ KOŞULLARDA SAKLANMASı, ÖZELLIKLE SALÇA, PEKMEZ GIBI BESINLERI BOŞ DETERJAN VE ILAÇ KUTULARı, PLASTIK KAPLARDA SAKLANMASı KANSERE NEDEN OLMAKTADıR. 47

YANLIŞ BESLENME SEBZE, MEYVE TÜKETIMININ AZ OLMASı, VITAMINDEN ZENGIN GıDALARıN TÜKETILMEMESI KANSERIN OLUŞUMUNU ARTTıRAN FAKTÖRLERDIR. 48

BESLENMEDE NELERE DIKKAT ETMELIYIZ Doğru ve dengeli beslenmeliyiz. Besinleri saklamak için özel yapılmış kaplarda (boyalı olmayan cam kaplar gibi), küf oluşmayacak şekilde uygun ısıda ve sürede saklanmalıdır. 49

BESLENMEDE NELERE DIKKAT ETMELIYIZ Besinleri doğru şekilde pişirmeliyiz. Kızartma, tütsüleme, mangal yerine fırında pişirme, haşlama gibi yöntemler kanser etkenlerinin oluşumunu önler. Besinleri hatalı pişirme vitamin kaybına yol açar. Ör: Haşlayıp suyunu dökme. . . 50

BESLENMEDE NELERE DIKKAT ETMELIYIZ Hazır gıda kullanımını azaltmalıyız. Özellikle çocuklarımızın hazır gıdalara yönelmesini önlemeli, beslenmelerinde doğal gıdalara yer vermeliyiz. 51

BESLENMEDE NELERE DIKKAT ETMELIYIZ Tuzu daha az tüketmeliyiz. Turşu, ketçap, hardal, salamura zeytin gibi tuzu fazla olan besinlerden kendimizi ve çocuklarımızı uzak tutmalıyız. Masada tuz bulundurmamalıyız. 52

BESLENMEDE NELERE DIKKAT ETMELIYIZ Posalı gıdaların tüketimini arttırmalıyız. Sebze ve meyve tüketimini artırmalıyız. Özellikle; ağız, yemek borusu, akciğer, mide, kolon ve rektum kanserlerinin oluşumunu önlemektedir. 53

HAREKETSİZ YAŞAM HAREKETSIZLIK SAĞLıĞıMıZı BIRÇOK YÖNDEN OLUMSUZ ETKILEMEKTEDIR. GÜNLÜK DÜZENLI YAPıLAN AKTIVITELER KOLON, MEME VE AKCIĞER KANSERINE KARŞı KORUYUCUDUR. 54

HAREKETSİZ YAŞAM HAREKETSIZLIK ŞIŞMANLıĞıN BIR NEDENIDIR VE ŞIŞMANLıĞıN NEDEN OLDUĞU KANSER RISKLERINI DE ARTTıRMAKTADıR. AŞıRı KILOLU BIREYLERDE ÖZELLIKLE MEME KANSERI, KALıNBAĞıRSAK-REKTUM VE KANSERI DAHA FAZLA GÖRÜLMEKTEDIR. 55

AŞIRI GÜNEŞ IŞINI OZON TABAKASıNıN INCELMESI ULTRAVIYOLE ıŞıNLARıNıN ZARARLı ETKILERINI ARTıRMıŞTıR. FAZLA GÜNEŞ ıŞıNıNA MARUZ KALMA CILT KANSERINE NEDEN OLMAKTADıR. FAZLA SOLARYUMA GIRMEKTE CILT KANSERINE NEDEN OLMAKTADıR. 56

VİRÜSLER Helicobacter Pylori Mide kanseri Hepatit C Virüsü Karaciğer kanseri Ebstein-Barr Virüsü Lenf kanseri Papilloma Virüsü Serviks kanseri riskini artırır. 57

RADYASYON Röntgen gibi radyasyona neden olan etkenlere fazla maruz kalma kanser nedenidir. Fazla cep telefonu kullanmakta kanserin etkenlerindendir. 58

KİMYASAL MADDELER Endüstride kullanılan bir çok kimyasal ajanın, kanser yapıcı özelliği vardır. Kimyasal maddeler akciğer, kemik iliği, prostat, cilt, mesane, burun-sinüs kanserine neden olmaktadır. (Plastik maddeler, temizlik maddeleri, böcek ve tarım ilaçları. . . ) 59

ÇEVRE KİRLİLİĞİ Hava kirliliğine neden olan etkenler, çöpler, sanayi atıkları gibi nedenler kanserin oluşum riskini arttırmaktadır. 60

GENETİK VE YAŞ Ailede kanser öyküsü risk faktörüdür. Birinci derece akrabalarında kanser öyküsü olan bireylerde kanser görülme sıklığı diğer insanlara göre daha fazladır. Yaş ilerledikçe kanser riski artmaktadır. 61

BELİRTİLER Vücudumuzda elle hissedilen şişlikler Siğil ve benlerde belirgin değişiklik 62

BELİRTİLER BEKLENMEYEN KANAMA VE AKıNTıLAR UZUN SÜREN SES KıSıKLıĞı VE ÖKSÜRÜK 63

BELİRTİLER UZUN SÜREN, IYILEŞMEYEN YARALAR YUTMA GÜÇLÜĞÜ VEYA HAZıMSıZLıK 64

BELİRTİLER TUVALET ALıŞKANLıKLARıNDA ANI DEĞIŞIKLIK AÇıKLANAMAYAN KILO KAYBı 65

BU DEĞİŞİKLİKLER GÖRÜLDÜĞÜNDE BİR HEKİME BAŞVURMAYI İHMAL ETMEYİNİZ. 66

KADINLARDA SIK GÖRÜLEN KANSER TÜRLERİ Meme Kanseri Rahim-Yumurtalık Kanseri Mide-Bağırsak Kanseri Akciğer Kanseri 67

ERKEKLERDE SIK GÖRÜLEN KANSER TÜRLERİ Akciğer Kanseri Prostat Kanseri Mide Kanseri Bağırsak Kanseri 68

KANSER VE TEDAVİ Cerrahi, Radyoterapi, Kemoterapi, Hormonoterapi, İmmünoterapi, başlıca tedavi yöntemleridir. 69

KANSERDEN KORUNMA KANSER YAPıCı ETKENLERDEN UZAK DURMALıYıZ, ÇOCUKLARıMıZı DA UZAK TUTMALıYıZ. DENGELI VE DOĞRU BESLENMELIYIZ. BOL SEBZE VE MEYVE TÜKETMELIYIZ. 70

KANSERDEN KORUNMA DÜZENLI EGZERSIZ YAPMALıYıZ, ÇOCUKLARıMıZıN FIZIKSEL AKTIVITELERINI DESTEKLEMELIYIZ. İDEAL KILOMUZU KORUMALıYıZ. 71

SIGARA VE TÜTÜN KULLANMAYıNıZ. SIGARA KULLANıLAN YERLERDE BULUNMAYıNıZ. 72

ÇOCUKLARıNıZı SIGARA DUMANıNA MARUZ BıRAKMAYıNıZ. 73

Güneşin ultraviyole ışınlarına maruz kalmayınız. Çocuklarınızı ve kendinizi fazla güneşte kalmaktan koruyunuz. 74

KANSERDEN KORUNMA ÇOCUKLARıNıZıN, YAZ AYLARıNDA 11. 00 -15. 00 ARASı GÜNEŞE ÇıKARKEN KORUYUCU KREMLER SÜRMELERINI VE GENIŞ KENARLı ŞAPKA TAKMALARıNı SAĞLAYıNıZ. GÜNEŞTE YANMAKTAN KAÇıNıNıZ. SOLARYUMU TERCIH ETMEYINIZ. 75

HAVA VE ÇEVRE KIRLILIĞINE NEDEN OLAN SANAYI TESISLERINDEN UZAK DURUNUZ. Hem kendimiz hem de çocuklarımızın geleceği için çevremizi korumalıyız. 76

GEREKMEDIKÇE RÖNTGEN FILMI ÇEKTIRMEYINIZ. CEP TELEFONUNUN RADYASYON ETKISINDEN KENDIMIZI VE ÇOCUKLARıMıZı KORUMALıYıZ. 77

DÜZENLI SAĞLıK KONTROLLERINIZI, RUTIN TETKIKLERINIZI, ÖZEL MUAYENELERI( ÖRNEĞIN KADıNLAR IÇIN JINEKOLOJIK MUAYENE, ERKEKLER IÇIN PROSTAT MUAYENESI ) YAPTıRıNıZ. 78

ERKEN TANININ AVANTAJLARI TEDAVI ŞANSıNı ARTTıRıR. TEDAVIYI KOLAYLAŞTıRıR. TEDAVI GIDERLERINI AZALTıR. DOKU VE ORGAN KAYBıNı EN AZA INDIRIR. 79

TARAMA NEDİR ? Herhangi bir şikayeti olmayan, rutin yıllık klinik muayeneleri normal bulunan, taranan hastalık açısından risk faktörü bulunmayan kişilere hastalık belirti vermeden önce belli yaşlarda belli aralıklarla önerilen belirli tarama testlerinin yapılmasıdır. 80

ERKEN TANI İÇİN UYGULANAN TARAMALAR

KANSER İLE SAVAŞ KANSERE NEDEN OLAN ETKENLERIN YOK EDILMESI, SAĞLıKLı KIŞILERIN DÜZENLI TARANMASı, ERKEN TEŞHIS VE UYGUN TEDAVI KANSER ILE SAVAŞıN TEMEL ILKELERIDIR. 82

KANSERDE ERKEN TEŞHIS HAYAT KURTARABILIR. KANSERDEN DEĞIL GEÇ KALıNMAKTAN KORKULMALıDıR. 83

KANSER KADER DEĞİLDİR KORUNMAK ELİMİZDE! İSTANBUL SAĞLIK MÜDÜRLÜĞÜ EĞİTİM ŞUBE 2010 84

KALP-DAMAR HASTALIKLARI • Sağlıksız beslenme sonucu ortaya çıkan tehlikeli hastalıklardan biri de kalp-damar hastalıklarıdır. 85

KÜRESEL ÖLÜM NEDENLERİ

KAN DOLAŞIMI 87 Büyük Kan Dolaşımı; Kalbin sol karıncığından(ventrikül) çıkan O 2’den zengin kan, aort ve atar damar(arter) yoluyla tüm vücuda(organ, doku ve hücrelere) gider. Oradan CO 2’den zengin kapiller (kılcal damar) ve toplar damarlar(ven) yoluyla kalbin sağ kulakcığına gelir. Buna Büyük Dolaşım denir. Küçük Kan Dolaşımı; Kalbin sağ karıncığından(ventrikül) çıkan CO 2’den zengin kan, büyük pülmoner arterle akciğere gelir. Burada CO 2’yi bırakıp O 2’yi alan kan, büyük pülmoner venle kalbin sol kulakcığına(atriyum) gelir. Buna da Küçük Dolaşım denir. Kalbin sol tarafında, diğerine göre kan basıncı yüksektir(60/70/80 mm/Hg), sağ tarafında ise kan basıncı daha düşüktür(10/20/30 mm/Hg),

KALP HASTALIKLARI 88 Doğumsal(Konjenital) Kalp Hastalıkları; ü VSD(Ventriküler Septal Defekt); Karıncıklar arası bölge delik, ü ASD(Atrial Septal Defekt); Kulakcıklar arası bölge delik, ü FT(Fallot Tetrolojisi); VSD+Pülmoner arter ağzında stenoz(darlık), ü BDT(Büyük Damar Transpozisyonu); Sağdan çıkan büyük damarlar soldan, soldan çıkan büyük damarlar sağdan çıkar, Akkiz(Sonradan Gelişen) Kalp Hastalıkları; ü Endokardit(ARA’ya bağlı); Kalbin iç tabakası iltihabı, ü İnfektif Endokardit/Bakteriyel Endokardit; Kalbin iç tabakası iltihabı, ü Kalp Yetmezliği; Kanın pompalanmasında yetersizlik ve kalpte büyüme, ü Koroner Kalp Hastalığı; v Anjino pektoris; Ateroskleroza bağlı olarak koronerlerde darlık, v Myokart enfarktüsü; Ateroskleroza bağlı olarak koronerlerde tıkanma,

DOĞUMSAL(KONJENİTAL) KALP HASTALIKLARI VE NEDENLERİ 89 Doğumsal(Konjenital) Kalp Hastalıkları; ü VSD(Ventriküler Septal Defekt); Karıncıklar arası bölge delik, ü ASD(Atrial Septal Defekt); Kulakcıklar arası bölge delik, ü FT(Fallot Tetrolojisi); VSD+Pülmoner arter ağzında stenoz(darlık), ü BDT(Büyük Damar Transpozisyonu); Sağdan çıkan büyük damarlar soldan, soldan çıkan büyük damarlar sağdan çıkar, Nedenleri; ü Kalıtım, akraba evlilikleri, ü Gebeliğe özen; v Teratojenik ilaçlar, v İntrauterin enfeksiyonlar(TORCHS), özellikle Kızamıkcık, v Radyasyon(Röntgen vb. ), v Diyabetli anne(Diyabetik Anne Bebeği-Büyük Damar Transpozisyonu),

DOĞUMSAL(KONJENİTAL) KALP HASTALIKLARI (VSD-ASD-FT-DBT) Canlı doğan bebekten yaklaşık %1’ konjenital kalp hastalığı ile doğmakta, Bu sıklık ölü doğanlarda % 5, düşüklerde % 10 -25, Doğumsal kalp hastalığı olan bebeklerin büyük çoğunluğu doğmadan ölmekte, (Doğal seleksiyon), Yaş Sayı % 0 -3 497 38. 2 4 -10 630 48. 5 11+ 173 1300 100. 0 Toplam 90

AKKİZ(SONRADAN GELİŞEN) KALP HASTALIKLARI VE NEDENLERİ 91 Akkiz(Sonradan Gelişen) Kalp Hastalıkları; ü Endokardit(ARA’ya bağlı); Kalbin iç tabakası iltihabı, ü İnfektif Endokardit/Bakteriyel Endokardit; Kalbin iç tabakası iltihabı, ü Kalp Yetmezliği; Kanın pompalanmasında yetersizlik ve kalpte büyüme, ü Koroner Kalp Hastalığı; v Anjino pektoris; Ateroskleroza bağlı olarak koronerlerde darlık, v Myokart enfarktüsü; Ateroskleroza bağlı olarak koronerlerde tıkanma, Nedenleri; ü A grubu beta hemolitik streptekok enf. (Tonsilit, Kızıl, İmpetigo, Erizipel/Yılancık), ü Yüksek kolestrol(Hiperkolestrolemi)-Ateroskleroz, ü HDL; Damarlardan karaciğere gelen, aterosklerozdan koruyan, ü LDL; Sindirim sistemi ve karaciğerden damarlara gelen ve ateroskleroza eğilimi artıran, ü Sigara, alkol, ü Yanlış beslenme(aşırı tuzlu, aşırı yağlı beslenme), ü Aşırı Kilo(BKİ 25’in üzerinde), ü Hipertansiyon, ü Diyabet, ü Stres(Distres), ü Hareketsiz yaşam, ü Uygun olmayan ağız hijyeni ve yetersiz diş fırçalama,

KOLESTROL’ÜN İŞLEVLERİ, YARARLARI VE GEREKLİLİĞİ, ü Hücre zarlarının inşası ve bakımı, hücre sinyal iletimi ve membranlardaki iyon ve protein geçirgenliği, ü Steroid yapılı hormonların üretimi (Kortizol, Aldosteron, Cinsiyet hormonları; Testosteron, Östrojen, Progestron), ü D vit. üretimi ve yağda eriyen vitaminlerin (A, D, E, K) metabolizması, ü Safra üretimi( yağların sindirimi için), ü Sinir hücreleri arasındaki sinapslar’ın güçlenmesi, Bağışıklık sistemi hücrelerinin işlevleri, için kolesterol gereklidir. ü 92

KOLESTEROL TÜRLERİ Saf kolesterol kanda akışkan değildir, Akışkan olması için karaciğerde proteinle bağlanarak lipoprotein’e dönüşmesi gerekir, Lipoproteinler’in yüzeyinde yer alan proteinler, kolesterolün hangi hücrelerden alınıp, hangi hücrelere taşınacağını belirler, 93 İki önemli lipoprotein(kolestrol türü) var, Ø LDL(Low Density Lipoproteins=Düşük Yoğunluklu Lipoprotein) KÖTÜ KOLESTROL); ü Karaciğer ve bağırsaklardan damarlara ve hücrelere gitme eğiliminde, ü Vücutta gerekli işleri yaptıktan sonra(hücre zarı onarımı, iletim, sinaps, steroid hormonlar, vitamin üretimi ve metabolizması vb. ) kanda yüksek olması halinde fazlası, damar duvarında ATEROM denen sert ve yağlı tabaka oluşturma eğilimindedir, Ø HDL(High Density Lipoproteins=Yüksek Yoğunluklu Lipoprotein) İYİ KOLESTROL; ü Hücrelerde sentezlenen kolesterolü(LDL), kullanıldıktan sonra atılması için karaciğere taşır, ü Kolesterolü damar duvarlarından uzaklaştırır, ü Ateromlardaki(aterosklerotik plak) kolesterolü karaciğere geri taşır,

KOLESTEROL SAĞLANAN KAYNAKLAR VE DIŞARI ATILIMI Besin Yoluyla Dışarıdan Alınan; 2. Vücut Tarafından Üretilen; ü Karaciğer (Günlük üretimin %20 -25’i), ü İnce bağırsaklar (Safra ve besin yoluyla bağırsaklara giren 1200 -1300 mgr kolesterolün yarısı kana geçer), ü Adrenal bezler(Böbrek üstü bezleri), ü Üreme organları(Testis, Over), 1. l ü ü v Besin yoluyla alınan kolesteroldeki artış, vücutta üretilenin azalmasına yol açar, Besinlerden gelen miktarın azalması, vücutta üretilenin artmasına yol açar, l Dışarı Atılım; Karaciğerden safra aracılığıyla olur, v 94 70 kg bir insanın vücudunda 35 gr kolesterol vardır, Günlük vücuttaki üretim 1 gr, Besin yoluyla alınan 200 -300 gr,

KOLESTEROL DÜZEYLERİ l ü ü ü Total Kolesterol; 130 -199 mg/dl. Normal İstenen Düzey, 200 -239 mg/dl. Sınırda Yüksek, 240 mg/dl. ve üzeri Çok Yüksek, LDL Kolesterol; 130 mg/dl’nin altı Normal İstenen Düzey, 131 -159 mg/dl. Sınırda Yüksek, 160 mg/dl. ve üzeri Çok Yüksek, ü HDL Kolesterol(Normal İstenen Düzey); Normalde 35 -60 mg/dl, Kadında 55 mg/dl, Erkekte 45 mg/dl, l Total Kolesterolün HDL Kolesterole oranı 5: 1 olması uygundur. l ü ü 95

YÜKSEK LDL KOLESTEROLÜN ZARARLARI Ateromların Oluşumu (Ateroskleroz/Arteriyoskleroz); Hangi organ damarında oluşursa o organa ilişkin hastalık ve bulgular gelişir, ü Koronerlerde Aterom; Koroner arter hastalığı, AP, MI, ü Böbrek damarlarında Aterom; Hipertansiyon, böbrek yetmezliği, ü Beyin damarlarında Aterom; Hemipleji(İnme), ü Pankreas damarlarında Aterom; Diyabet, 96 Safra taşları oluşumu,

YÜKSEK LDL KOLESTEROLE NEDEN OLAN ETMENLER 1. 2. 3. 4. 5. 6. v Ø Ø Ø 97 Kalıtım; Ailesel yüksek kolesterol erken yaşta kalp krizine yol açabilir, Aşırı Kilo; Bel çevresi erkeklerde 100, kadınlarda 85 cm üzeri ve BKİ 25’in üzeri, (Kilo verme LDL’nin düşmesine, HDL’nin yükselmesine eğilimi artırır), Yanlış Beslenme, Hareketsiz Yaşam, Stres, Sigara ve Alkol; Aşırı Alkol; Karaciğer ve kalp başta olmak üzere tüm organlara zarar verir, Hipertansiyona yol açar, Ttigliseriti yükseltir,

HDL KOLESTEROLÜN YÜKSELMESİNİ LDL KOLESTEROLÜN DÜŞMESİNİ ETKİLEYEN ÖNERİLER 1. Önerilen Besinler; ü ü Kuru baklagiller, ü Balık ve balık yağı, ü Tekli doymamış yağ (Zeytin yağı), ü 98 Lifli gıdalar, tam buğday, kepekli , çavdar ve yulaf ekmeği, ü 2. Uzak Durulması Önerilen Besinler; ü Katı bitkisel yağlar(margarin) ü Şeker ve hamurlu gıdalar, ü Kolestrolden zengin gıdalar(böbrek, ciğer, beyin vb. ), Omega 3’lü gıdalar (Balık, Zeytin ve zeytin yağı, Keten ü tohumu , Ceviz, Badem, Fındık, ü Fıstık vb. , ), ü Tüm sebze ve meyveler, (Marul, ıspanak, semizotu gibi yeşil sebzeler, Portakal, mandalina, elma, üzüm, nar, kızılcık, yaban mersini, avakoda vb. , ), ü Soğan, sarımsak (Günde yarım soğan HDL’yi %25 artırır, Yoğurt(Probiyotik), Yağlı süt, peynir, krema, vb. ), Aşırı tuz tüketimi, 3. Önerilen Yaşam; ü Düzenli egzersiz/ yürüyüş, ü Sigara ve aşırı alkolden uzak durma, ü Kilo verme ve kiloyu koruma, ü Stres yönetimi,

22 ÜLKEDE YAPILAN BİR DEĞERLENDİRMEDE; ü ü ü Kalp hastası olduğunu bilenlerden sigara içmeye devam edenler: Avrupa Ülkeleri’nde %17, Türkiye’de %23, Kalp sorunu olanların %35’i şişman(Türkiye) ü 99 50 yaş altında kalp hastalığı olma olasılığı: Avrupa Ülkeleri’nde %13, Türkiye’de %23,

EN ÇOK GÖRÜLEN KALP HASTALIKLARI (TÜRKİYE) 10 0

KORONER KALP HASTALIĞI(KKH) (KORONER ARTER HASTALIĞI/ATEROSKLEROTİK KALP HASTALIĞI) Kalbe kan ve oksijen sağlayan kılcal damarların(koroner) giderek daralmasına koroner arter hastalığı denir, Genellikle kolesterol’ün oluşturduğu plaklar (ateroskleroz) neden olur, Koroner arterler daraldıkça, kalbe giden kan giderek azalır, Bu durum göğüs ağrısı, nefes darlığı, kalp krizi gibi belirtilere yol açar, Türkiye’de en sık ölüm nedeni, 40 yaşından sonra koroner kalp hastalığı olasılığı: Erkeklerde %49, Kadınlarda %32, Yaş arttıkça risk de artmakta, 10 1

KALP YETMEZLİĞİ Tanım: ü Doğuşta ya da sonradan edinilen bir hastalık sonucu, kalbin görevini tam yapamaması durumu, ü Hemen bütün kalp hastalıklarının son dönemlerinde ortaya çıkan bir klinik tablo, ü Kadınlar arasında daha yaygın, sıklığı yaşla artar, 65 yaş üzerinde %o 30 -130 arasında değişir, Nedenleri: v Sol Kalp Yetmezliği; ü Mitral veya aort kapak hastalığı, ü Koroner yetmezlik, ü Hipertansiyon(Yüksek kan basıncı), v Sağ Kalp Yetmezliği; ü Doğuştan kalp hastalıkları(VSD, ASD, FT), ü Kronik akciğer hastalıkları(KOAH=Kronik bronşit, Bronşektazi, Astım bronşiyale, Amfizem), v Belirtileri; ü Nefes darlığı, ü Öksürük, ü Ayaklarda ödem, ü Röntgende(telegram) büyümüş kalp görüntüsü, ü EKG’de değişiklikler, 10 2

KALP KRİZİ (MYOKART ENFARKTÜSÜ) Kalbin kasına yeteri kadar kanoksijen gitmemesi ve kas hücrelerinin canlılığını yitirmesi sonucu ortaya çıkan klinik tabloya kalp krizi (miyokard enfarktüsü) denir. 10 3

KALP KRİZİ (MYOKART ENFARKTÜSÜ) Koroner arterlerdeki tıkanma kalp kasına kan ve oksijen akışını engeller, bu da o bölgedeki kalp hücrelerinin ölümüne neden olur. Bazı vakalar belirtisiz geçirilir, EKG’de görülebilir (Kolleteralleşme/ damarlaşma) ME Belirtileri; Göğüste şiddetli ağrı(bıçak saplanır gibi), Göğüste basınç hissi, sıkışma, Sol kola ve bileğe vuran ağrı, Sararma, soğuk terleme, Tansiyonda ani yükselme, Nabız sayısında artma(taşikardi), Bulantı, kusma, ü ü ü ü 10 4

10 5

KALP HASTALIĞI RİSK FAKTÖRLERİ 10 6 Değiştirilemeyen Risk Faktörleri; ü Kalıtım(Genetik), Ailede kalp hastalığı öyküsü, ü Yaş, ü Cinsiyet (Erkek), Değiştirilebilen Risk Faktörleri; ü Sigara alışkanlığı, ü Yanlış beslenme, ü Yüksek kan kolestrol düzeyi, ü Stres(distres), ü Hareketsiz yaşam, ü Obezite, ü Hipertansiyon ü Diabetes mellitus(Şeker hastalığı),

KALP HASTALIKLARINDAN GENEL KORUNMA ÖNERİLERİ Akraba evliliğinden kaçınma, Gebeliğe özen(Konjenital Kalp Hastalıkları); v Genetik danışmanlık, v Teratojenik ilaçlar, v İntrauterin enfeksiyonlar(TORCHS), v Radyasyon(Röntgen vb. ), v Diyabetli anne(Diyabetik Anne Bebeği-Büyük Damar Transpozisyonu), Sigara içilmemeli, Doğru beslenme, bol sebze meyve yemeli, günlük yağ ve tuz alımı azaltılmalı, Düzenli egzersiz, yürüyüş(Günde 30 -45 dak. ), Uygun kiloyu koruma(BKİ=Kilo(Kg)/Boy(m) karesi), Yüksek tansiyon tedavi edilmeli, Stres(distres) yönetimi, stresle baş etme, Kolesterol düşürülmeli, Diyabete dikkat etmeli, yüksek şeker düşürülmeli, Doğum Kontrol Haplarına dikkat, Zaman zaman SAĞLIK KONTROLLERİ, 107

10 8 KAYNAK: PROF. DR. ÖMER R. ÖNDER ANKARA ÜNIVERSITESI SAĞLıK BILIMLERI FAKÜLTESI

ENDOKRİN SİSTEMİ BOZUKLUKLARI • Sağlıksız beslenme sonucu ortaya çıkan tehlikeli olabilecek hastalıklardan biri de endokrin sistemi bozukluklarıdır. • Diyabet • Tiroit Bezi Rahatsızlıkları 109

TEŞEKKÜRLER… 110
- Slides: 110